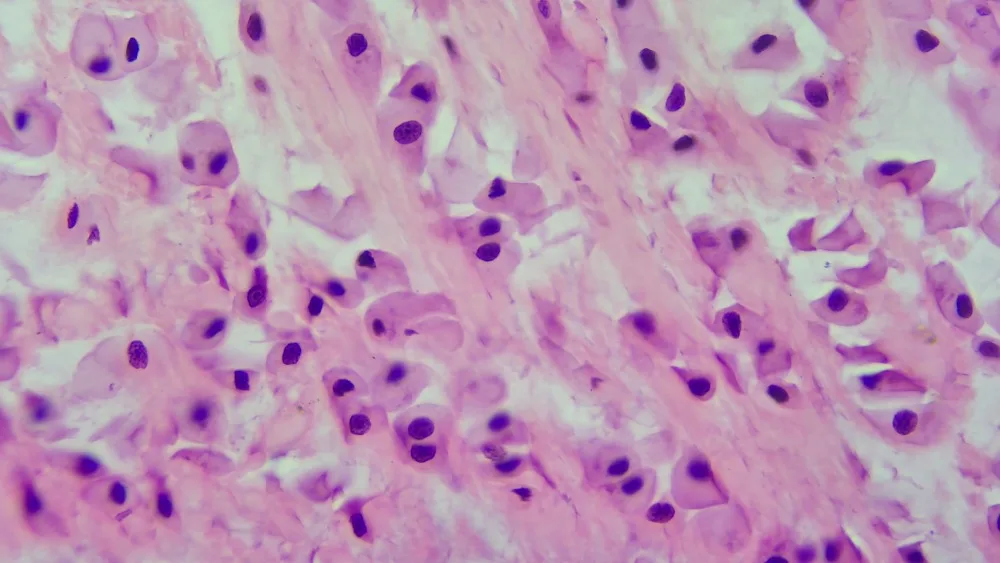
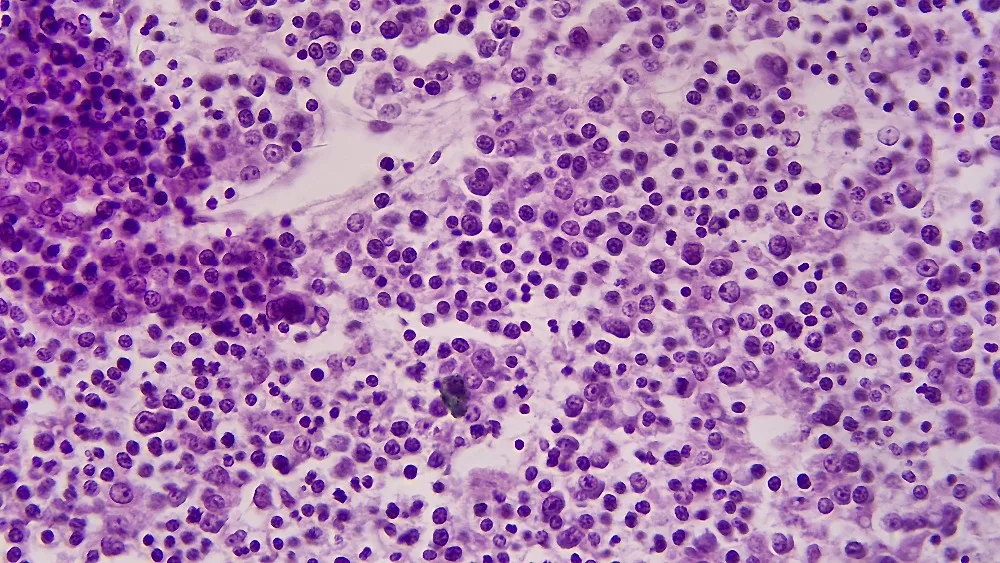

Профессиональный лабораторный Биологический микроскоп 40X - 1000X 1600X 2000X, Тринокулярный Медицинский микроскоп + видеокамера 37MP HDMI USB
Eakins Micscope Store - Надежность 97%
Более 6538 подписчиков, дата открытия магазина 18.09.2017
- Положительные оценки: 98% (1989)
- Соответствие описанию: 98%
- Отвечает на сообщения: 96%
- Скорость отправки: 96%
Последнее обновление: 09.03.2022
Оптическая система
Оптическая система с коррекцией конечного цвета
Головка для просмотра
Наклонная монокулярная головка 30 °
30 ° Наклонный бинокль, интерпупиллярное расстояние: 50-75 мм, ± 5 диоптрий регулируемый
Окуляр
Широкий полевой план окуляра PL10X/20 мм с/без сетки; PL10X/20 мм с/без указателя
Цель
Ахроматическая цель (4X, 10X, 40X, 100X)
Nosepiece
Четырехместный элемент
Рамка
Коаксиальный грубой и тонкой регулировки, с грубой регулировкой стоп и регулировки герметичности, диапазон: 25 мм, Точность: 0,002 мм. 3W светодиодный, центр, предустановленное интенсивность регулируется, внешний широкий диапазон напряжения переменного тока адаптер переменного тока, 100V-240V_AC50/60Hz вход переменного тока, DC7.5V 2A выход.
Сцена
140mmx132мм двухслойная Механическая сцена, диапазон движения: 50mmx76мм, Точность: 0,1 мм.
Конденсатор
N.A.1.25 Abbe конденсатор с диафрагмой радужной оболочки

-
EyepiecePL10X/20mm
-
HDMI resoltion1080P@60FPS
-
Image storageSupport
-
ObjectivePlan achromatic objective( 4X, 10X, 40X, 100X)
-
Optical format1/2.3 inch
-
Optical SystemFinite color corrected optical system
-
Output interfaceHDMI USB
-
Viewing Head30° inclined monocular head
-
Вес логистики8.500
-
Выдвижной тубусТринокуляр
-
Каждая упаковка1
-
Коэффициент увеличения500X-1500X
-
МатериалМеталл
-
Минимальная единица измерения100000017
-
Название брендаEakins
-
Номер модели4X, 10X, 40X, 100X
-
ОсновыБиологический микроскоп
-
ОсобенностиHigh Definition
-
Продано Вsell_by_piece
-
ПроисхождениеКитай
-
Размер логистики - высота (см)50
-
Размер логистики - длина (см)45
-
Размер логистики - ширина (см)26
-
СертификацияЕвропейский сертификат соответствия





